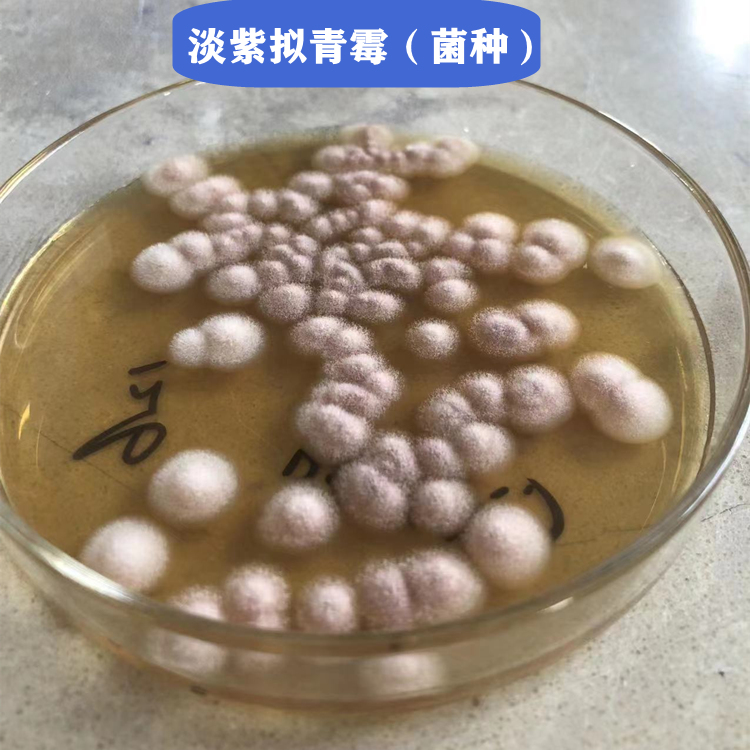
淡紫拟青霉杀虫剂生产厂家

淡紫拟青霉杀虫剂生产厂家
¥158
1元/公斤
起订
¥155
5元/公斤
起订
¥155
25元/公斤
起订
湖北 更新日期:2026-04-16
产品详情:
- 中文名称:
- 淡紫拟青霉
- 品牌:
- 湖北博蓝化工有限公司
- 产地:
- 武汉
- 保存条件:
- 常温
- 纯度规格:
- 99%
- 产品类别:
- 化工原料
- 剂型:
- 可湿性粉剂
- 别名:
- 淡紫拟青霉杀虫剂生产厂家
- 淡紫拟青霉杀虫剂生产厂家:
- 淡紫拟青霉杀虫剂生产厂家
公司简介
湖北博蓝化工有限公司是华中地区专业从事化工原料等产品的研究,开发,生产,销售,服务为一体的综合型企业。公司多年来经过对国内市场的分析调查,整合出了一套独特的企业产品文化,不仅注重开发自己的特色产品,同时与国内外各大型厂家和科研单位合作选择品质质量最有的原料供应商。使公司产品系列更加多样化,产品质量与价格优势更加明显,形成了自营与经营的完美结合,使公司业务获得了更好发展。并与国内众多科研单位保持着良好的合作关系。公司生产的丁酰肼,抑芽丹、2,4-滴,缩节胺,三氟啶磺隆,嘧硫草醚,甲嘧磺隆,氟胺磺隆,氟唑磺隆,三氟啶磺隆钠盐、丁酰肼(比久)、S-诱抗素、2.4D除草剂、2.4滴酸除草剂、高效氯氰菊酯、氯稀炔菊酯、高效氟氯氰菊酯、苯甲羟肟酸、水杨羟肟酸、烷基羟肟酸、烷基羟肟酸钠、高铁酸钾原料生产厂家等产品在国内占据独特优势,产品质优价廉,深受客户喜爱。
企业文化:公司始终以“三新”为企业的灵魂,创立之初就一直秉承“科技创新、思路创新、服务创新”的企业理念,深入思考“企业自身、客户需求、企业与客户关系”的三点问题,最终形成了以“科技创新、思路创新、服务升创新”为宗旨的企业营销观。
企业目标:立足现在,长远考虑,稳步发展,打造华中地区化工原料品牌供应商。
本公司所有产品均保证质量合格,价格优势,欢迎广大客户来电咨询订购!我们的宗旨:"注重质量、诚信经营、热诚服务
| 成立日期 | (10年) |
| 注册资本 | 100万 |
| 员工人数 | 10-50人 |
| 年营业额 | ¥ 500万-1000万 |
| 经营模式 | 工厂 |
| 主营行业 | 农药中间体,原料药,兽药原料,激素类,解热镇痛药 |
淡紫拟青霉相关厂家报价
-

- 淡紫拟青霉
- 河南沃咖斯生物科技有限公司 VIP
- 2026-04-19
- 询价
-

- 淡紫拟青霉
- 潍坊瑞辰生物科技有限公司
- 2026-03-16
- 询价
-

- 地衣芽孢杆菌
- 河南沃咖斯生物科技有限公司 VIP
- 2026-04-19
- 询价
-

- “6-氨基青霉烷酸”551-16-6高纯中间体
- 湖北阡陌生物科技有限公司 VIP
- 2026-04-18
- ¥50
-
- 永固紫RL
- 武汉裕清嘉衡药业有限公司 VIP
- 2026-04-18
- 询价